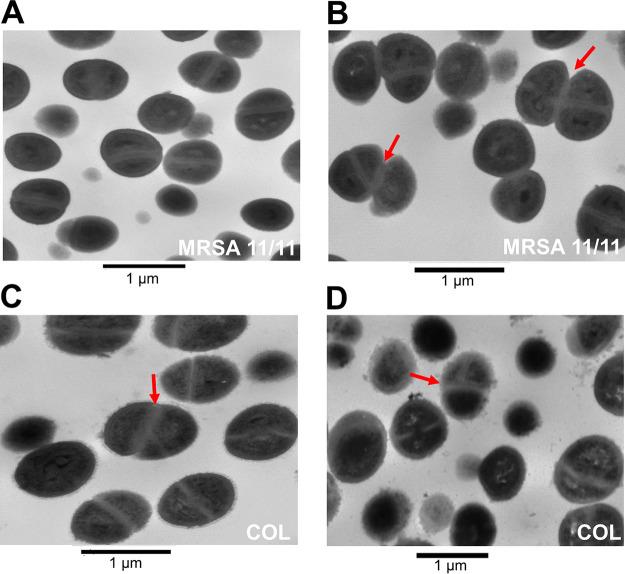
https://cdn.ncbi.nlm.nih.gov/pmc/blobs/59c7/9769754/76d19185c33b/spectrum.03422-22-f003.jpg

碳酸氢钠对响应型和非响应型耐甲氧西林金黄色葡萄球菌壁磷壁酸合成和β-内酰胺敏化的影响。
Influence of Sodium Bicarbonate on Wall Teichoic Acid Synthesis and β-Lactam Sensitization in NaHCO-Responsive and Nonresponsive Methicillin-Resistant Staphylococcus aureus.
机构信息
The Lundquist Institute, Torrance, California, USA.
Laboratory of Molecular Microbiology of Bacterial Pathogens, UCIBIO, Applied Molecular Biosciences Unit, Department of Life Sciences, Nova School of Science and Technology, Universidade Nova de Lisboa, Caparica, Portugal.
出版信息
Microbiol Spectr. 2022 Dec 21;10(6):e0342222. doi: 10.1128/spectrum.03422-22. Epub 2022 Nov 15.
Methicillin-resistant Staphylococcus aureus (MRSA) strains pose major treatment challenges due to their innate resistance to most β-lactams under standard antimicrobial susceptibility testing conditions. A novel phenotype among MRSA, termed "NaHCO responsiveness," where certain strains display increased susceptibility to β-lactams in the presence of NaHCO, has been identified among a relatively large proportion of MRSA isolates. One underlying mechanism of NaHCO responsiveness appears to be related to decreased expression and altered functionality of several genes and proteins involved in cell wall synthesis and maturation. Here, we studied the impact of NaHCO on wall teichoic acid (WTA) synthesis, a process intimately linked to peptidoglycan (PG) synthesis and functionality, in NaHCO-responsive versus -nonresponsive MRSA isolates. NaHCO sensitized responsive MRSA strains to cefuroxime, a specific penicillin-binding protein 2 (PBP2)-inhibitory β-lactam known to synergize with early WTA synthesis inhibitors (e.g., ticlopidine). Combining cefuroxime with ticlopidine with or without NaHCO suggested that these latter two agents target the same step in WTA synthesis. Further, NaHCO decreased the abundance and molecular weight of WTA only in responsive strains. Additionally, NaHCO stimulated increased autolysis and aberrant cell division in responsive strains, two phenotypes associated with disruption of WTA synthesis. Of note, studies of key genes involved in the WTA biosynthetic pathway (e.g., , , , and ) indicated that the inhibitory impact of NaHCO on WTA biosynthesis in responsive strains likely occurred posttranslationally. MRSA is generally viewed as resistant to standard β-lactam antibiotics. However, a NaHCO-responsive phenotype is observed in a substantial proportion of clinical MRSA strains , i.e., isolates which demonstrate enhanced susceptibility to standard β-lactam antibiotics (e.g., oxacillin) in the presence of NaHCO. This phenotype correlates with increased MRSA clearance by standard β-lactam antibiotics, suggesting that patients with infections caused by such MRSA strains might be amenable to treatment with β-lactams. The mechanism(s) behind this phenotype is not fully understood but appears to involve -PBP2a production and maturation axes. Our study adds significantly to this body of knowledge in terms of additional mechanistic targets of NaHCO in selected MRSA strains. This investigation demonstrates that NaHCO has direct impacts on S. aureus wall teichoic acid biosynthesis in NaHCO-responsive MRSA. These findings provide an additional target for new agents being designed to synergistically kill MRSA using β-lactam antibiotics.
耐甲氧西林金黄色葡萄球菌(MRSA)菌株由于其在标准抗菌药敏试验条件下对大多数β-内酰胺类药物的固有耐药性,给治疗带来了重大挑战。在相当大比例的 MRSA 分离株中,已经发现了一种新的 MRSA 表型,称为“NaHCO 反应性”,其中某些菌株在存在 NaHCO 的情况下对β-内酰胺类药物的敏感性增加。NaHCO 反应性的一个潜在机制似乎与参与细胞壁合成和成熟的几个基因和蛋白质的表达减少和功能改变有关。在这里,我们研究了 NaHCO 对壁磷壁酸(WTA)合成的影响,这一过程与肽聚糖(PG)合成和功能密切相关,在 NaHCO 反应性与非反应性 MRSA 分离株中。NaHCO 使敏感的反应性 MRSA 菌株对头孢呋辛(一种已知与早期 WTA 合成抑制剂(如噻氯匹定)协同作用的特定青霉素结合蛋白 2(PBP2)抑制剂β-内酰胺)敏感。头孢呋辛联合噻氯匹定,无论是否存在 NaHCO,均表明这两种药物靶向 WTA 合成的相同步骤。此外,NaHCO 仅在反应性菌株中降低 WTA 的丰度和分子量。此外,NaHCO 刺激反应性菌株的自溶和异常细胞分裂增加,这两种表型与 WTA 合成的破坏有关。值得注意的是,对 WTA 生物合成途径中涉及的关键基因(例如 、 、 、和 )的研究表明,NaHCO 对反应性菌株中 WTA 生物合成的抑制作用可能发生在翻译后水平。MRSA 通常被认为对标准β-内酰胺类抗生素具有耐药性。然而,在相当大比例的临床 MRSA 菌株中观察到 NaHCO 反应性表型,即分离株在存在 NaHCO 的情况下对标准β-内酰胺类抗生素(如苯唑西林)表现出更高的敏感性。这种表型与标准β-内酰胺类抗生素对 MRSA 的清除率增加相关,这表明由此类 MRSA 菌株引起的感染的患者可能对β-内酰胺类抗生素的治疗有效。这种表型的机制尚不完全清楚,但似乎涉及β-PBP2a 的产生和成熟轴。我们的研究在选定的 MRSA 菌株中,为 NaHCO 的其他机制靶点提供了重要的补充。本研究表明,NaHCO 对 NaHCO 反应性 MRSA 的细胞壁磷壁酸生物合成有直接影响。这些发现为使用β-内酰胺类抗生素协同杀灭 MRSA 的新型药物提供了新的靶点。